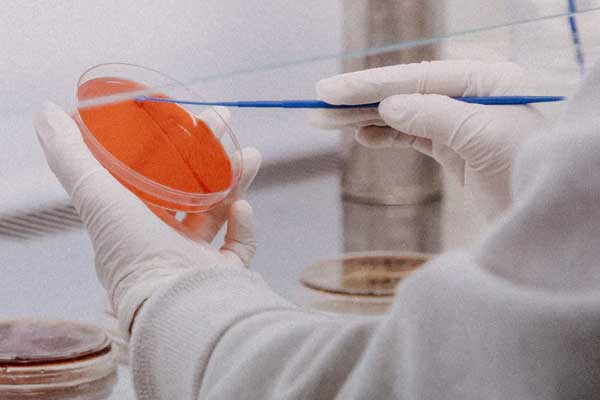
�Ž����и�����۸��Ŀ��

一、九江考研培训机构
打算报班学习,选择教学机构很关键,适合自己的辅导机构才能发挥理想的教学效果。九江的考研培训机构是比较多的,而且每家都有各自的教学特色,多选择几家对比考察,对报班学习很有好处,九江中公考研有专业的课程教研团队,根据历年考试题型,不断提炼升级,打造针对性特色教学服务,结合不同学员的实际情况设计教学方案,因材施教确保培训效果。

二、九江考研辅导班价格价目表
| 课程形式 | 课程班型 | 课程介绍 | 班型价格 | |
| 集训课程 | 全科标准班 | 普研专业 | 1.公共课系统教学,专业课定向辅导,完整搭建知识框架;2.以题代讲,掌握考点应用能力;3.早自习师资带背,巩固考点记忆。 | 34800元起(详情电询) |
| 艺术 | 40800元起(详情电询) | |||
| 英管综 | 30800元起(详情电询) | |||
| 全科集训班 | 普研专业 | 1.增加小班辅导课程,针对性补弱培优,突破式强化拔高;2.增加小班能量包,解决个性化问题。 | 53800元起(详情电询) | |
| 艺术 | 59800元起(详情电询) | |||
| 英管综 | 49800元起(详情电询) | |||
| 直通集训营 | 普研专业 | 在以上基础上增加培优讲练班,根据各阶段学习内容辅以专项试题教学,深层次夯实基础。 | 69800元起(详情电询) | |
| 艺术 | 75800元起(详情电询) | |||
| 英管综 | 65800元起(详情电询) | |||
| 网校课程 | 全科标准班 | 公共课+专业课标准辅导,全科系统疏理,构建知识框架 | 19800元起(详情电询) | |
| 全科加强班 | 在标准班的基础上增加“45天暑期集训”课程+复试标准班(艺术手绘30天暑期集训) | 27800元起(详情电询) | ||
| 全科集训A班 | 在全科加强班基础上增加“30天冲刺集训+小班辅导+复试集训班 | 39800元起(详情电询) | ||
| 全科集训B班 | 在全科集训A班基础上增加培优讲练班 | 47800元起(详情电询) | ||

三、考研辅导班有用吗
参加研究生考试,能不能成功上岸,对于每个考生都是一次重要的人生转折,而选择什么样的备考方式则显得比较重要。自学需要有较强的知识基础和自制能力,若有不足,便会增加学习压力,严重的可能前功尽弃,直接影响考试成绩;而选择考研辅导班,会由专业的老师带学,不仅可以帮助学员找到正确的学习方法,而且遇到学习难题还能够得到及时解决,在学习效率和备考质量方面都有很大帮助。
